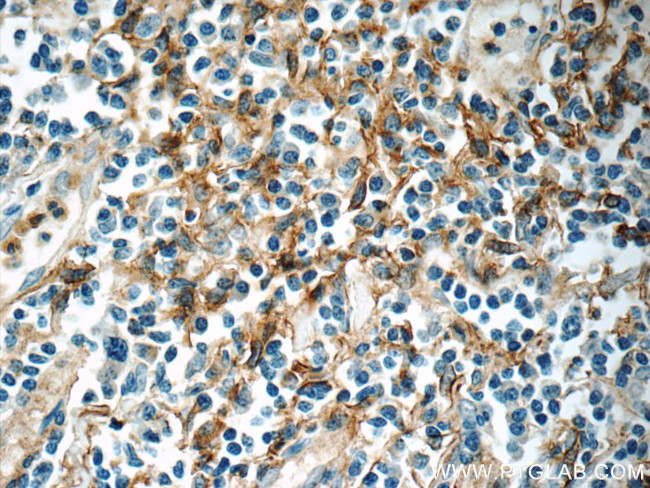
ENOX1 Antibody in Immunohistochemistry (Paraffin) (IHC (P))

Search
Proteintech
ENOX1 Polyclonal Antibody
{{$productOrderCtrl.translations['antibody.pdp.commerceCard.promotion.promotions']}}
{{$productOrderCtrl.translations['antibody.pdp.commerceCard.promotion.viewpromo']}}
{{$productOrderCtrl.translations['antibody.pdp.commerceCard.promotion.promocode']}}: {{promo.promoCode}} {{promo.promoTitle}} {{promo.promoDescription}}. {{$productOrderCtrl.translations['antibody.pdp.commerceCard.promotion.learnmore']}}
产品信息
23750-1-AP
种属反应
宿主/亚型
分类
类型
抗原
偶联物
形式
浓度
规格
纯化类型
保存液
内含物
保存条件
运输条件
产品详细信息
Immunogen sequence: TQFEQIVAV FNASTRQKAW DHFSKAQRKN IDIWRKHSEE LRNAQSEQLM GIRREEEMEM SDDENCDSPT KKMRVDESAL AAQAYALKEE NDSLRWQLDA YRNEVELLKQ EKEQLFRTEE NLTKDQQLQF LQQTMQGMQQ QLLTIQEELN NKKSELEQAK EEQSHTQALL KVLQEQLKGT KELVETNGHS HEDSNEINVL TVALVNQDRE NNIEKRSQGL KSEKEALLIG IISTFLHVHP FGANIEYLWS YMQQLDSKIS ANEIEMLLMR LPRMFKQEFT GVGATLEKRW KLCAFEGIKT T (344-643 aa encoded by BC024178)
靶标信息
Probably acts as a terminal oxidase of plasma electron transport from cytosolic NAD(P)H via hydroquinones to acceptors at the cell surface. Hydroquinone oxidase activity alternates with a protein disulfide-thiol interchange/oxidoreductase activity which may control physical membrane displacements associated with vesicle budding or cell enlargement. The activities oscillate with a period length of 24 minutes and play a role in control of the ultradian cellular biological clock.
仅用于科研。不用于诊断过程。未经明确授权不得转售。
篇参考文献 (0)
生物信息学
蛋白别名: anti-cancer drug-insensitive hydroquinone (NADH) oxidase with protein disulfide-tiol interchange activity; cCNOX; candidate growth-related and time keeping constitutive hydroquinone (NADH) oxidase; Candidate growth-related and time keeping constitutive hydroquinone [NADH] oxidase; cCNOX; Cell proliferation-inducing gene 38 protein; cNOX; Constitutive Ecto-NOX; ecto-NADPH oxidase disulfide-thiol exchanger 1; Ecto-NOX disulfide-thiol exchanger 1; unnamed protein product
基因别名: bA64J21.1; cCNOX; CNOX; ENOX1; PIG38
UniProt ID: (Human) Q8TC92
Entrez Gene ID: (Human) 55068